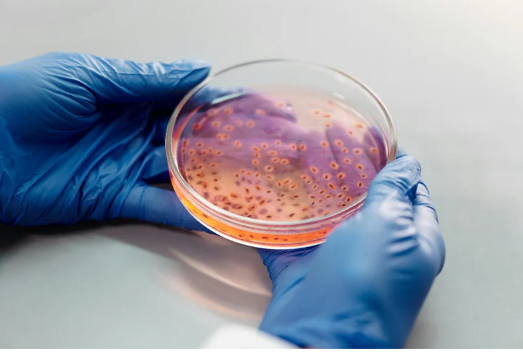

Primeiro infecção, na sequência inflamação!
Na artrite reativa (ARe) uma infecção no sistema digestivo ou urinário geralmente ocorre antes que a inflamação se desenvolva nas articulações. Como tal, acredita-se que ocorra como uma
reação a uma infecção.
Manifestações Sistêmicas da Artrite Reativa: Além das Articulações
ARe pode causar inflamação e dor nas articulações, pele, olhos, bexiga, genitais e membranas mucosas, sendo possível também afetar a coluna vertebral, apesar de incomum.


Embora a ARe tenha sintomas que se limitam no tempo, com diminuição progressiva de 03 a 12 meses, a condição comumente é cíclica. Os estudos demonstram que algumas pessoas com ARe podem desenvolver uma forma crônica de artrite.
